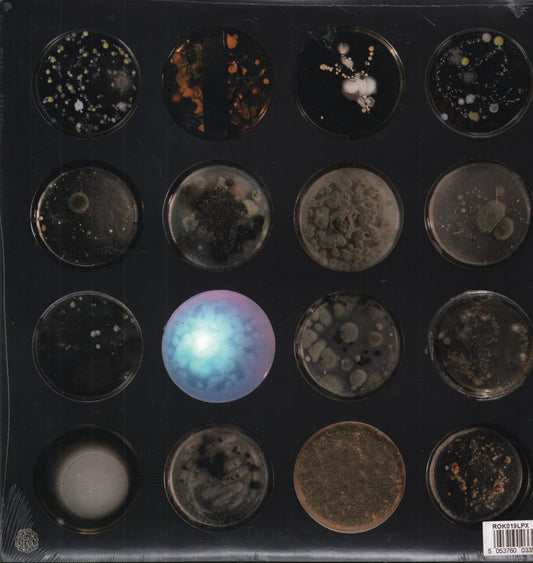

Collection: Coloured Vinyl
-
Sektarism
La Mort De L'Infidèle
Double LPZanjeer Zani Productions - France - 2017ZZP014LP - EX-/EX+limited edition 4 track double clear vinyl lp in gatefold sleeve with inners and posterRegular price £16.99 GBPRegular priceUnit price / perSale price £16.99 GBP -
Mirror Queen
Scaffolds Of The Sky
LPTee Pee - USA - 2015173A - VG+/EX7 track clear vinyl LP with inner, download card and still in opened stickered shrink. Crease to ...Regular price £9.99 GBPRegular priceUnit price / perSale price £9.99 GBP -
Amber Arcades
Barefoot On Diamond Road
LPFire - Europe - 2023FIRELP702S - EX-/EX+Limited Edition Indies Only Silver Vinyl lp with Download Card brand new sealed has info sticker ...Regular price £14.99 GBPRegular priceUnit price / perSale price £14.99 GBP -
Various Artists
Haunted Presence
LPNumero Group - Europe - 2024NUM566LPC2 - NEWLimited 2LP set on ghost power silver coloured vinylRegular price £30.99 GBPRegular priceUnit price / perSale price £30.99 GBP -
Naughty By Nature
Naughtiest
LPTommy Boy - Europe - 2024TB55711 - NEWRemastered Red VinylRegular price £17.99 GBPRegular priceUnit price / perSale price £17.99 GBP -
Motley Crue
Cancelled
12 InchBig Machine Rock - Europe - 20243011560 - NEWLimited red & black splatter vinylRegular price £21.99 GBPRegular priceUnit price / perSale price £21.99 GBP -
Various Artists
Psychedelic Scene
Double LPDecca - Europe - 20246561551 - NEWPressed on Pink VinylRegular price £33.99 GBPRegular priceUnit price / perSale price £33.99 GBP -
Thee Sacred Souls
Got a Story to Tell
LPDaptone - Europe - 2024DAP078LPC - NEWLimited edition magneta colour vinylRegular price £22.99 GBPRegular priceUnit price / perSale price £22.99 GBP -
Groundhogs
Blues Obituary
LPFire - Europe - 2024FIRELP506C - NEWLimited gold vinyl reissueRegular price £23.99 GBPRegular priceUnit price / perSale price £23.99 GBP -
Seun Kuti And Egypt 80
Heavier Yet (Lays The Crownless Head)
LPRecord Kicks - USA - 2024RKX096 - NEWLimited clear vinyl editionRegular price £29.99 GBPRegular priceUnit price / perSale price £29.99 GBP -
Pretty Boy Floyd
Set The Night On Fire
LPDeadline Music - USA - 2020CLO1847 - NEWlimited edition pink vinyl LP. still sealedRegular price £19.99 GBPRegular priceUnit price / perSale price £19.99 GBP -
Ben Howard
Is It
LPIsland - Europe - 20235522970 - NEWlimited edition 10 track marble grey vinyl lp with poster brand new sealed has info sticker on fr...Regular price £14.99 GBPRegular priceUnit price / perSale price £14.99 GBP -
Opeth
Blackwater Park
Double LPMusic For Nations and Sony Music - UK - 20211943987321 - EX-/EX-limited edition 20th anniversary edition double dark transparent vinyl in gatefold sleeve with bo...Regular price £60.00 GBPRegular priceUnit price / perSale price £60.00 GBP -
Sonic Experience / Various
Untitled
7 InchStrictly Underground - UK - 1993STURFLEXI - /VG+clear flexi disc has no print on labelsRegular price £3.99 GBPRegular priceUnit price / perSale price £3.99 GBP -
Little Richard
Settin’ The Woods On Fire: The Reprise Rarities
LPOmnivore Recordings - Europe - 20240810075114669 - NEW13 track pressed on orange vinylRegular price £20.99 GBPRegular priceUnit price / perSale price £20.99 GBP -
Harry Gregson-Williams
Gladiator II
Double LPDecca - Europe - 20247513651 - NEWLimited transparent sand coloured vinyl 2LP set in g'fold sleeveRegular price £34.99 GBPRegular priceUnit price / perSale price £34.99 GBP -
Molly Nilsson
Un-American Activities
LPNight School - Europe - 2024DSA055 - NEWWhite Vinyl LP. still sealedRegular price £14.99 GBPRegular priceUnit price / perSale price £14.99 GBP -
Phobophobes
Miniature World
LPRa-Ra Rok - UK - 2018ROK019LPX - NEWlimited edition 10 track clear vinyl brand new sealedRegular price £9.99 GBPRegular priceUnit price / perSale price £9.99 GBP -
Groundhogs
Scratching The Surface
LPFire - Europe - 2024FIRELP505C - NEWLimited gold vinyl reissueRegular price £23.99 GBPRegular priceUnit price / perSale price £23.99 GBP -
Jake Bugg
A Modern Day Distraction
LPEurope - 202419802820051 - NEWIndies Exclusive Clear VinylRegular price £18.99 GBPRegular priceUnit price / perSale price £18.99 GBP -
Bartees Strange
Horror (Dinked Edition #314)
LP4Ad - Europe - 20254AD0746LPXE - NEWDinked Edition #314 / 12 Track Limited Edition Exclusive To Dinked Stores Red Vinyl with Signed P...Regular price £27.99 GBPRegular priceUnit price / perSale price £27.99 GBP -
Robert Plant And Alison Krauss
Raising Sand
Double LPRounder - USA - 20151166190751 - EX/EXClear vinyl Newbury Comic exclusive pressing 2 LP set limited to 1000 copies. Still sealed with i...Regular price £75.99 GBPRegular priceUnit price / perSale price £75.99 GBP -
Ronnie Wood and The Ronnie Wood Band
Mr Luck: A Tribute to Jimmy Reed Live at the Royal Albert Hall
Double LPBMG - Europe - 20214050538683233 - NEWlimited edition 18 track double blue smoke-effect vinyl lp in gatefold sleeve brand new sealed ha...Regular price £12.99 GBPRegular priceUnit price / perSale price £12.99 GBP -
UK Subs
Flood of Lies
LPFall Out - UK - 2024FALLLP018 - NEW2024 remaster on transparent ochre vinylRegular price £20.99 GBPRegular priceUnit price / perSale price £20.99 GBP -
Black Sabbath
Forbidden
LPBMG - Europe - 2024BMGCAT925LP - NEWNewly remixed by Tony Iommi, on limited clear vinylRegular price £26.99 GBPRegular priceUnit price / perSale price £26.99 GBP -
Black Sabbath
Cross Purposes
LPBMG - Europe - 2024BMGCAT924LP - NEW2024 remaster of the classic 1994 LP, on limited clear vinylRegular price £26.99 GBPRegular priceUnit price / perSale price £26.99 GBP -
Francobollo
Long Live Life
LPSquare Leg - UK - 2017SQUARELEG010LPC - NEWlimited edition 12 track green vinyl in gatefold sleeve brand new sealed has info sticker on frontRegular price £12.99 GBPRegular priceUnit price / perSale price £12.99 GBP -
Free Love
Inside (Dinked Edition #229)
LPLost Map - Europe - 2023LAT030D - NEWDinked Edition #229 / 10 Track Limited Edition Exclusive To Dinked Stores 'Blood Red Embryo' Viny...Regular price £10.99 GBPRegular priceUnit price / perSale price £10.99 GBP -
Bodega
Broken Equipment
LPWhat's Your Rupture? - Europe - 2022WYR0122LPD - NEWDinked Edition #155 / 12 Track Limited Edition Exclusive To Dinked Stores Clear Teal Vinyl with B...Regular price £18.99 GBPRegular priceUnit price / perSale price £18.99 GBP -
Gnod
La Mort Du Sens
LPRocket - Europe - 2021LAUNCH239D - NEWDinked Edition #143 / 5 Track Limited Edition Exclusive To Dinked Stores Tri Colour Splatter Viny...Regular price £19.99 GBPRegular priceUnit price / perSale price £19.99 GBP -
Storm Corrosion
Storm Corrosion
Double LPKscope - Europe - 2024KSCOPE1240 - NEWKScope Reissue of 2012 Collaboration Between Steven Wilson and Mikael Åkerfeldt. Indie Exclusive ...Regular price £47.99 GBPRegular priceUnit price / perSale price £47.99 GBP -
JD McPherson
Nite Owls
LPNew West - Europe - 2024LPNW5859IE - NEWLimited Edition One Time Pressing Indie Exclusive Splatter Vinyl. Includes Autographed Archival P...Regular price £29.99 GBPRegular priceUnit price / perSale price £29.99 GBP -
Ólafur Arnalds & Alice Sara Ott
Chopin Project
LPDecca - Europe - 20244876132 - NEWBlack & White Marble VinylRegular price £30.99 GBPRegular priceUnit price / perSale price £30.99 GBP -
Daughtry
Shock To the System (Part One)
LPBig Machine - Europe - 20243011467 - NEWLight Blue Translucent VinylRegular price £21.99 GBPRegular priceUnit price / perSale price £21.99 GBP -
Crows
Reason Enough
LPBad Vibrations - Europe - 2024BADVIBES15V12 - NEWFrosted Clear Vinyl with Download codeRegular price £23.99 GBPRegular priceUnit price / perSale price £23.99 GBP -
Echo And The Bunnymen
What Are You Going To Do With Your Life? (25th Anniversary Edition)
LPLondon - Europe - 2024LMS1725111 - NEWLimited edition crystal clear vinylRegular price £22.99 GBPRegular priceUnit price / perSale price £22.99 GBP